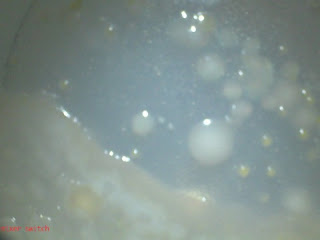

Just another day!
So much happened today it makes me giggle! Why? Because it didn't feel rushed or too crazy and the diversity of things that happened is quite something.
Evie had a friend over all day, they spent most of the day working on a play they plan to perform in June. They helped me make flowers and bugs our of spice drops for an event I have on Friday, we walked to the store on some errands, Evie baked a quick bread before her friend got here, Scott baked enough bread to feed most of the block, I worked on our other blog and various internet projects. And then, in the afternoon (like I said, busy day) we looked at a variety of things under our wicked cool microscope, including some bacteria Evie has been growing for a few days in her homemade incubator. We also walked the neighborhood dog, brought cake to a neighborhood friend and read books. Evie plowed through the biography of Clara Barton AGAIN (time number 632, I think!)
The evening included more Mille Bornes (see yesterday's post) and more Dancing with the Stars.
The pictures are the items baked in our oven today and a few microscope snapshots--busy, busy day!

2 comments:
Okay I am not a cake eater...but that cake looks yummy and well of course all the bread looks delicious...you have been busy.
I just came over to your website to get more information about your microscope...and lookie here you blogged today about it...funny! It doesn't look like it is compatible to a MAC...bummer deal. WE have a little money to spend for school...and thought a microscope would be a good choice.
Your day definitely looks like it was well lived!
Miss you guys!
It is available for a Mac (that is what we have) although it may be an older model. I heard they briefly stopped making the mac software and now you have to buy a CD once you have the microscope. The company is Digital Blue, I am sure their website has more info.
It is a great microscope. no tiny wiggly eye-piece, you can measure things, highlight them, take pictures etc. etc.
Post a Comment